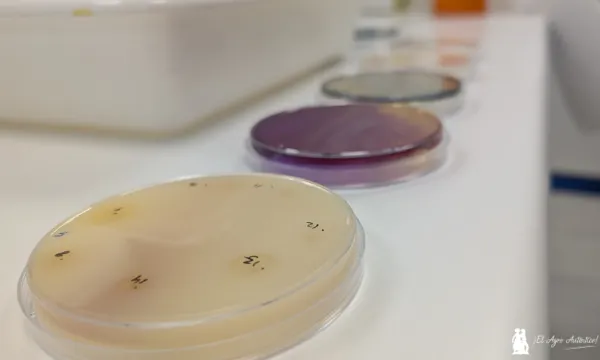
Cepas de microorganismos en laboratorio / agroautentico.com

Tabla de Contenidos
Agronova Biotech suma seis fábricas: dos en la región de Murcia, una en Portugal, una en Sevilla, otra en Perú y otra más en EEUU
Salto hacia adelante para formar un gran conglomerado de media docena de empresas bajo el paraguas de Agronova Biotech. Son Asfertglobal, Probelte, Impello, Mundeco, Proin y ARM. “Más otras que vendrán en breve. Queremos hacer algo grande en la agricultura”, expresa el CEO de la nueva plataforma empresarial, Joel Jerónimo, refiriéndose al punto de inflexión que supone en el mundo agro la sinergia entre empresas fabricantes y de I+D que tocan todos los pilares de la bioestimulación, la bionutrición y el biocontrol.
Molina de Segura, Murcia
Nos citamos en Molina de Segura (Murcia) para conocer este ambicioso proyecto en las instalaciones de Agronova Biotech, ligadas a Probelte. Fabricación y laboratorios que conocemos in situ de la mano de sus responsables. De este modo Agronova aglutina ya seis plantas de producción: dos en Murcia (Molina de Segura y Fortuna), una en Sevilla, otra en Portugal (Santarém), otra en Perú y también en EEUU.
La suma de todas ellas crea un portafolio riquísimo en todo tipo de soluciones que van desde las microalgas pasando por un vasto panel de microorganismos hasta incluso soluciones digitales que indican cuándo es el momento óptimo para aplicar los productos. Además la plataforma cuenta con una gran biblioteca de datos, Biological as Services (BaaS) que marca el paso futuro por donde caminará el sector.

Biofertilizantes, bioestimulantes y biocontrol
Durante el recorrido por los laboratorios y posteriormente por la fábrica nos muestran la I+D actual y cómo se fabrican estos biotecnológicos. En catálogo están algunos de los productos de mayor valor añadido en las tres familias.
Así, Agronova Biotech en biofertilizantes ofrece soluciones microbiológicas como Bulhnova, Kiplant AllGrip o Bioprón para incrementar el uso eficiente de nutrientes reduciendo a la mitad el uso de fertilización química por parte del agricultor.
En la familia de los bioestimulantes podemos nombrar Eckosil, Spirunol y Ekky (AirEkky, PowerEkky y SoilEkky). Y en cuanto a protección de cultivos, herramientas de biocontrol son Belthirul, Botrybel, Kiplant VS-04 o Cuperdem, entre otras.

Dentro de los laboratorios de Agronova Biotech
Jorge Malo, responsable de investigación, y Juan Moreno, responsable de desarrollo, nos hacen un minucioso recorrido por los distintos laboratorios como son el microbiológico, entomatología, fitopatología o biología molecular. 230 cepas de microorganismos propias y desarrolladas in-house atesoran este trabajo. Un cepario que se amplía cada año: 500 caracterizaciones de cepas con potencial biotecnológico.
Todo lo anterior hay que entenderlo en el contexto actual. La evolución del marco regulatorio europeo, con caídas periódicas de registros, ha llevado a la compañía a adelantarse en el tiempo para poder reemplazar y renovar la estantería del productor con microorganismos con efectos en biofertilización, biocontrol o bioestimulación.
Así la identificación de microorganismos naturales, su selección, aislamiento, medios de cultivos y escalado en distintas fases para un posterior desarrollo, formulado, producción y lanzamiento comercial centran la labor científica de los equipos de estos investigadores. Conocemos en nuestra visita a algunas de estas personas que lo hacen posible como Marina, Laura y varias Marías.

El primer biofertilizante
Más en detalle nos hablan del que fuera el primer biofertilizante, Bioprón con dos microorganismos (fijadores de nitrógeno y solubilizadores de fósforo) que ha dado paso a la versión Bioprón Premium.
Además, nos muestran el origen de Bulhnova, con dos bacterias que funcionan en asociación con las raíces y con capacidades solubilizadoras también sobre zinc o potasio. “Un paso más es Bulhnova SP en polvo soluble que incrementa la concentración de microorganismos, hasta diez veces más de concentración y con menos dosis. Es muy estable e ideal para exportación”, describe Jorge Malo.

Saludamos a algunos miembros del equipo que realizan en el momento de nuestra visita distintas tareas, ya sea aislando colonias de microorganismos, ya sea en control de calidad evaluando número de microorganismos y concentración adecuada.

Bioinsecticida microbiológico de referencia
En biocontrol Jorge Malo nos confiesa cuál es su ojito derecho, Belthirul, un bioinsecticida microbiológico frente a orugas que es como el buen vino. Eficacia contrastada año tras año con formulados en continua mejora tanto en líquido como en sólido.
Producto sin residuos que comenzó hace años como polvo mojable y que ha ido evolucionando a través de los distintos formulados.

Avanzamos en nuestro recorrido entrando de un laboratorio a otro sumergiéndonos en distintas áreas. Por ejemplo en el cepario, donde se seleccionan los microorganismos dependiendo de la capacidad – ya sea en biocontrol, biofertilización, bioestimulación… – que se busque.
Identificación de cepas acompañada de ensayos de metagenómica. Diversidad de parámetros se evalúan: cómo cambian las funciones, la influencia en el microbioma o en la estructura del suelo o la influencia en otros microorganismos para potenciar los beneficios sobre el suelo.
En cualquier caso comprendemos después de las explicaciones que en biofertilización una línea de investigación importante es la dirigida a minimizar el estrés hídrico en los cultivos y en el biocontrol la protección frente a hongos patógenos. Pero la lista es mucho más larga.

Planta piloto de fermentación y fitotrones
Nos situamos ya en el área de la fábrica. En ella hay una planta piloto de I+D donde se escala todo. “Un fermentador piloto de 30 litros nos facilita las cosas porque aquí podemos hacer los ajustes antes de ir a la producción en los grandes fermentadores que hay dentro de la fábrica”, explica Juan Moreno, que nos detallará a continuación los escalados que se llevan a cabo en diferentes direcciones.
En un espacio próximo hay dos fitotrones o cámaras de cultivo, una para biocontrol y otra para biofertilización. Marina Abellán y Michela Tamioso están con las manos en la masa cuando llegamos. Nos muestran cómo con los fitotrones se pueden emular las condiciones ambientales (temperatura, humedad, radiación, ventilación) del cultivo en cualquier parte del mundo. Después de pasar por aquí los siguientes ensayos se pueden continuar en invernadero o en campo, pero ya con gran parte del trabajo hecho gracias a los fitotrones.

Antes de entrar en el corazón de la fábrica, donde se ubican los biorreactores, vemos el laboratorio de producción de la propia fábrica, lo que nos sirve para comprender la trazabilidad de todo el proceso. Entre otras tareas en este laboratorio se mantienen los bancos de trabajo de trece bacterias, se preparan los inóculos o se controlan los procesos para garantizar la pureza.

Biorreactores o fermentadores
Y cerramos la visita adentrándonos en la planta de fermentación de bacterias. Aquí conocemos a Joaquín Rodríguez, responsable de planta, que nos guía durante el recorrido.
Hay cinco biorreactores o fermentadores de distintas capacidades de producción: 300 litros, 2.500 litros, 6.000 litros y dos biorreactores de 16.000 litros.
De aquí sale, por ejemplo, el biofungicida Botrybel, formulado a base de bacterias para control de hongos patógenos.
En salas anexas hay otros procesos como los de envasado de los productos.

Agradecemos a Agronova Biotech por habernos abierto las puertas de su I+D y mostrarnos la fabricación de estos productos que ya están marcando el camino actual y futuro de la agricultura.








